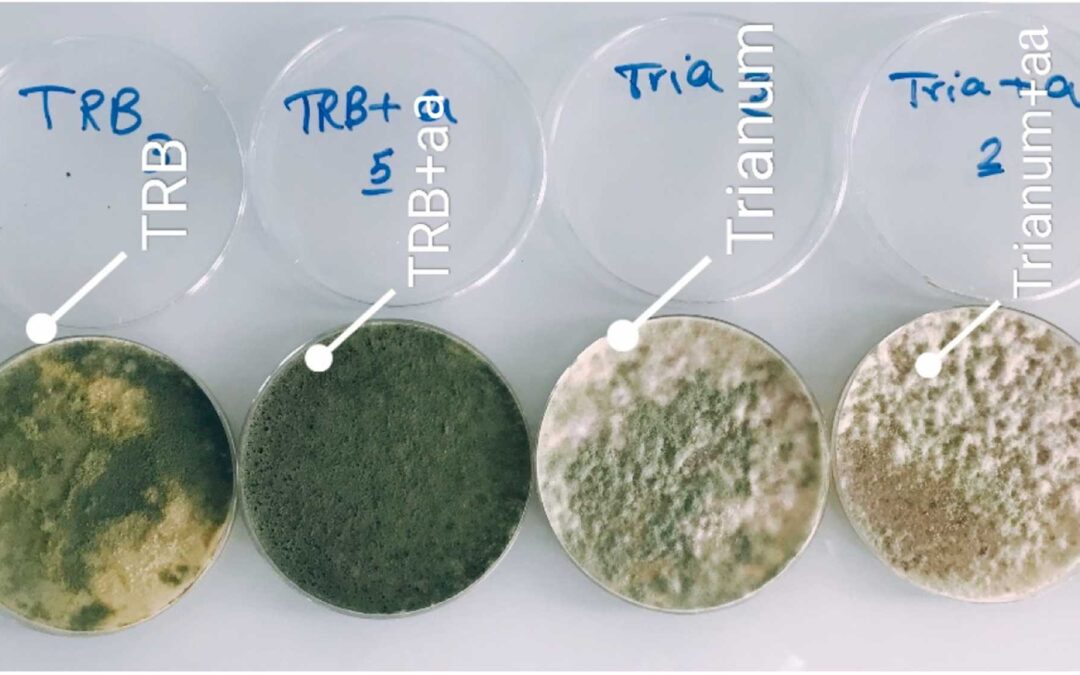

Formulation des agents de substances de biocontrôle
Une journée d’échange le 27 juin 2023
RDV à Maison-Alfort chez BPI France assister
Une journée pour faire le point sur les besoins, les verrous et les nouvelles pistes à explorer autour de la formulation dans le domaine du biocontrôle.
- Introduction « État de l’art” : contexte défi et alternative »
- Session « Outils technologique au service de la formulation »
- Session « Chimie verte : formulation adaptée au biocontrôle »
- Session « Réglementation dans le domaine du biocontrôle et appelle à projet en cours »
- Rendez-vous d’affaires en One to One
Rencontrez-nous
Dernière Actualité
Libérer le potentiel prometteur du Trichoderma dans la gestion des terrains de golf
Les Points forts du Trichoderma - Souche TrB Amélioration la respiration du sol grâce aux acides aminés organiques, favorisant l'activité microbienne et racinaire. Augmentation l'IBN de 37,1 % pendant le biocontrôle, améliorant l'utilisation des nutriments et la santé...
Nos actualités, nos évènements
Aucun résultat
La page demandée est introuvable. Essayez d'affiner votre recherche ou utilisez le panneau de navigation ci-dessus pour localiser l'article.
Contactez-nous
Nos Laboratoires
Laboratoires BIOPHYTECH
Siège Social
Espace Technologique – Bâtiment Discovery
Bloc B Route de L’Orme
91190 Saint-Aubin
Laboratoire de Montpellier
ZA des Avants
4, Avenue du Grand Chêne
34270 Saint-Mathieu-de-Treviers